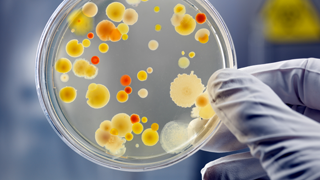

Accredited / Recognised by
- NABL ISO/IEC 17025 :2017
- Food Safety & Standards Authority of India (FSSAI)
- Food & Drugs Control Administration (FDA)-Govt of Gujarat
- Bureau of Indian Standard (BIS)
- Gujarat Pollution Control Board (GPCB)-Schedule-II Env. Auditor
- Agriculture Processed Export Development Authority (APEDA)
- AGMARK-Ministry of Agriculture Govt of India